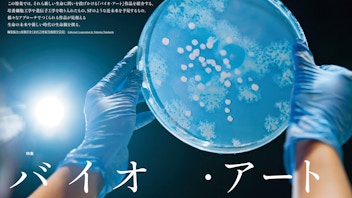

ゲルハルト・リヒターが世界初公開作品を六本木で発表。「Painting 1992–2017」がスタート
ドイツを代表するアーティスト、ゲルハルト・リヒターの最新個展「Painting 1992–2017」が12月15日、東京・六本木のWAKO WORKS OF ARTで開幕した。世界初公開を含む14点を展示する。

ドイツを代表するアーティスト、ゲルハルト・リヒターの最新個展「Painting 1992–2017」が12月15日、東京・六本木のWAKO WORKS OF ARTで開幕した。世界初公開を含む14点を展示する。
12月16日発売の『美術手帖』 2018年1月号の特集は「バイオ・アート」。編集長・岩渕貞哉による「Editor’s note」をお届けします。

12月16日発売の『美術手帖』2018年1月号は「バイオ・アート」特集。遺伝子組み換え技術や培養細胞工学など、バイオ・テクノロジーを用いて作品を制作するアーティストやサイエンティストたちの活動に迫る。

松坂屋名古屋店7階にある松坂屋美術館で「ミュシャ展 〜運命の女たち〜」が開催される。会期は2017年12月23日〜2018年2月18日。

川越市立美術館が開館15周年を記念し、川越生まれの画家・小村雪岱の展覧会を開催する。その多岐にわたる画業の中から挿絵に注目し、「雪岱調」と呼ばれる独自のスタイルに迫る。会期は2018年1月20日〜3月11日。

東京駅の北ドームに位置する東京ステーションギャラリーが、1988年の開館以来初となるコレクション展「鉄道絵画発→ピカソ行 コレクションのドア、ひらきます」を12月16日から開催する。

ネオンサインと植物を組み合わせたインスタレーションなどを手がける美術家・佐藤拓人が、東京・西麻布のCALM & PUNK GALLERYで個展を開催する。会期は12月23日〜2018年1月14日。

ユーモアと鋭い批評性を備えた作品をつくりあげてきた小沢剛が、千葉市美術館で大規模個展「不完全ーパラレルな美術史」を開催する。会期は2018年1月6日〜2月25日。

現在、モスクワの国立トレチャコフ美術館で開催中の第7回「モスクワ国際現代美術ビエンナーレ」のメインプロジェクト展「Clouds ⇆ Forests」でキュレーターを務めた長谷川祐子が、12月19日に東京藝術大学でキュレーション成果報告会を開催する。

東京・恵比寿で営業する現代アートに特化した書店・NADiff a/p/a/r/t が、来年で移転から10周年を迎えるのを前に店内をリニューアル。12月には、展覧会やトークなどの10周年プレイベントも多数開催される。

寺田倉庫が建築模型専用クラウド保管サービス「ARCHI−DEPOT STOCK」の提供を12月14日より開始。1ユニットあたり月額500円で建築模型を保管・管理できるほか、ウェブ上で作品の写真を公開することもできる。

gallery αMで開催中の光田ゆりキュレーションの企画展シリーズ、αMプロジェクト「鏡と穴-彫刻と写真の界面」。第6弾では柄澤健介を取り上げる。会期は2017年12月16日〜2018年2月3日。

原始的な生命体をモチーフとしたペインティングや彫刻作品を手がけてきた加藤泉が、リトグラフによる新作をペロタン東京で展示する。会期は12月15日〜28日。

毎年優れたメディア・アートやマンガなどのコンテンツを表彰・展示する「文化庁メディア芸術祭」が、離島初となる石垣島で開催された。これまで多く巡回されてきた都市圏とは異なる、その特徴を紹介する。

横浜美術館の2018年度の企画展のスケジュールが明らかになった。「ヌード NUDE -英国テート・コレクションより」や「モネ それからの100年」に加え、「イサム・ノグチと長谷川三郎―変わるものと変わらざるもの」など、計4つの企画展が開催される。

吉開菜央の初個展がAI KOWADA GALLERYで開催される。新作《静坐社》を含む映像作品の上映とともに、展示空間全体でのインスタレーションを発表する。会期は2017年12月16日〜24日。

フランスの画家、ポール・ゴーギャンの作品スタイルを決定づけたタヒチでの日々を描く映画「ゴーギャン タヒチ、楽園への旅」が2018年1月27日に公開。晩年のゴーギャンをヴァンサン・カッセルが演じる。

さまざまな分野で活動する作家たちが、「アーティストブック」の表現形式を追求した展覧会「本を、つくってみた-アーティストブックの制作と展示-」が開催されている。

2018年4月での閉鎖が決定している横浜・中区にある複合文化施設「BankART studio NYK」をめぐり、クラウドファンディングサービスで運営継続を願うプロジェクトが始まっている。

世界で初めて、全編が「動く油絵」で構成された映画『ゴッホ〜最期の手紙〜』が全国で上映中。謎に包まれたゴッホの死の真相を求めて旅する青年の物語が、ゴッホ自身の作品のようなタッチの油絵によって描かれている。